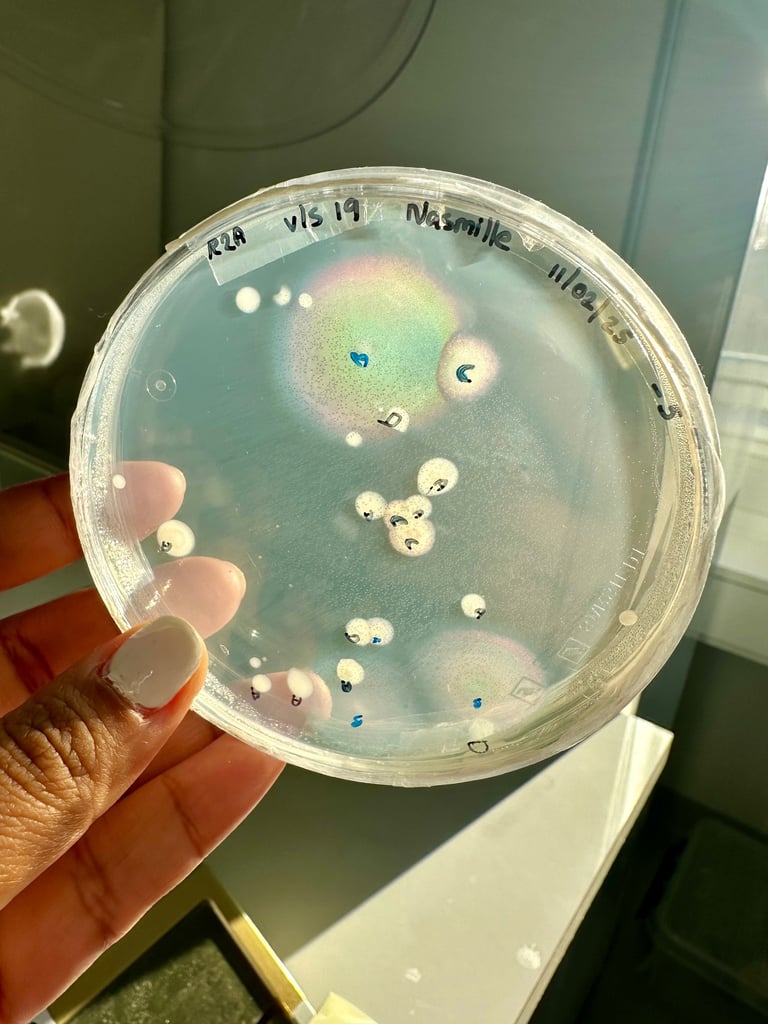
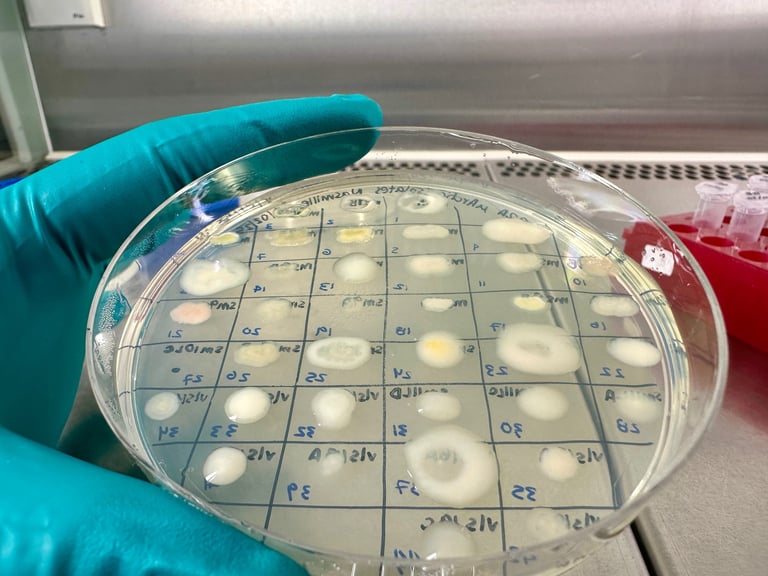
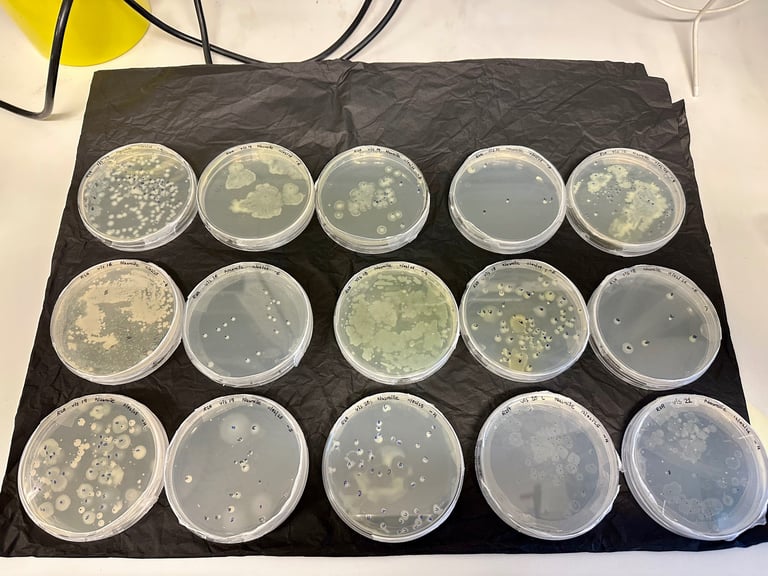
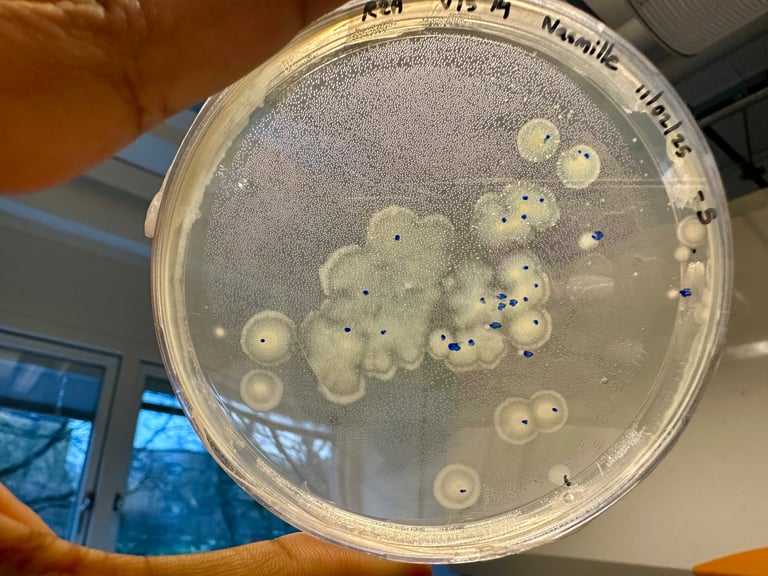

Mi primer año como becaria Marie Curie
Un repaso de mi primer año; desde el trabajo de campo, la vida en un nuevo país y los primeros pasos de mi independencia científica.
10/4/20253 min read


Me cuesta creer que ya haya pasado un año desde que llegué a Dinamarca para comenzar mi beca Marie Curie. El tiempo ha volado entre trabajo de campo, experimentos en el laboratorio, nuevas colaboraciones y muchos comienzos. Al mirar atrás, me siento profundamente agradecida y orgullosa de todo lo que ha ocurrido en estos doce meses.
Cuando llegué, tuve que lanzarme directamente al trabajo. Me esperaban muestras frescas de Abisko que debía procesar rápidamente. Ese comienzo tan intenso marcó el tono del año: un equilibrio entre el ritmo acelerado de los experimentos y el progreso constante y cuidadoso. En febrero ya tenía mi primer conjunto de aislamientos microbianos, y con ello, el proyecto empezó realmente a tomar forma.
Gran parte de este año ha girado en torno a explorar los musgos, los microbios y las diminutas moléculas que liberan. Me formé en nuevos instrumentos, realicé experimentos en cámaras climáticas y aprendí a medir emisiones de isopreno en distintas condiciones. Algunos de mis días favoritos fueron en el campo: ya fuera entre el barro de Bollemossen en otoño o en los largos días de verano en Abisko, recolectando musgos y arbustos bajo el sol de medianoche. El trabajo de campo tiene algo muy especial: te conecta con la esencia de la investigación y te recuerda por qué empezaste.
Además de la parte científica, tuve la oportunidad de compartir mis resultados en conferencias tanto en Dinamarca como en el extranjero, e incluso de presentar en Falling Walls Lab como finalista. Esa experiencia me animó a reflexionar sobre cómo los resultados de mi investigación podrían tener aplicaciones más allá del laboratorio, y sobre cómo aprovechar al máximo los descubrimientos de mi proyecto. El servicio Booster ofrecido dentro de la beca ha sido un apoyo increíble para ayudarme a pensar en el potencial de explotación de mis resultados, y en cómo transformarlos en impacto real sin dejar de construir mi carrera académica.
También fui invitada a contribuir a una colección temática de una revista científica, y el artículo que enviaré este mes es especialmente significativo para mí. Es mi último trabajo con mi mentor como coautor: una forma preciosa de honrar los proyectos que heredé de él y, al mismo tiempo, un símbolo de la transición hacia mi propia línea de investigación independiente. Es a la vez un homenaje y un nuevo comienzo.
Este año no ha sido solo investigación. También he realizado cursos de pedagogía y supervisión en la Universidad de Copenhague, que han sido muy valiosos ahora que empiezo a orientar a otras personas. Ha sido un verdadero placer trabajar con una asistente de investigación y dar la bienvenida a tres estudiantes al proyecto. Guiarles en sus primeros pasos científicos ha sido uno de los mayores logros de este año, y me llena de ilusión pensar en lo que vendrá después.
Por supuesto, no todo ha sido fácil. Mudarse de país nunca lo es: un nuevo idioma, nuevos colegas, nuevos sistemas. En lo personal, fue especialmente desafiante trasladarme con mi familia: mi hija empezando de cero en otro idioma, mi esposo buscando trabajo, todos alejándonos de lo conocido. La movilidad puede ser emocionante, pero también supone muchos retos. Ahora, al mirar atrás, me alegra pensar que la parte más dura ya pasó, y me enorgullece cómo nos hemos adaptado juntos.
También he empezado a explorar nuevas direcciones para mi trabajo: diseñar un juego de mesa científico, participar en actividades de divulgación y dar mis primeros pasos hacia una mayor independencia como investigadora. Una experiencia especialmente memorable fue participar en Science is Wonderful! en marzo, un evento que me transportó de nuevo a mis días como profesora y me recordó lo gratificante que es compartir la ciencia con mentes curiosas. Fue un placer unirme al equipo de Yi y representar a VOLT, y espero poder participar de nuevo el próximo marzo — esta vez con mi propio proyecto.
Al hacer balance, este año ha estado lleno de experimentos, muestras, viajes y nuevas colaboraciones. Pero más que eso, ha sido un año de crecimiento: aprender a equilibrar los proyectos heredados con mis propias ideas, desarrollar nuevas habilidades y ganar confianza mientras defino mi camino independiente como investigadora aquí en Dinamarca.
Estoy profundamente agradecida a la Unión Europea por apoyar esta beca Marie Skłodowska-Curie independiente, sin la cual nada de esto habría sido posible. También quiero agradecer a VOLT y a sus fundadores, así como a la Fundación Nacional Danesa de Investigación (DNRF), por su apoyo y por fomentar un entorno de investigación tan inspirador y dinámico. Y, por supuesto, mi más sincero agradecimiento a mis colegas, mentores y supervisores por su constante apoyo y orientación a lo largo de este primer año.
¡Que venga el segundo año — y el último de esta beca! Estoy lista para más trabajo de campo, más escritura y, sobre todo, para seguir descubriendo entre los musgos y los microbios.
Gallery

Nasmille Larke-Mejía Research
Exploring microbes' roles in environmental sustainability.
CONTACT ME:
© 2024. All rights reserved.
info@nasmillelarkemejia.com
Disclaimer: Some images and text on this website, including proofreading, have been created or refined using AI tools. For inquiries or further information, please contact me.